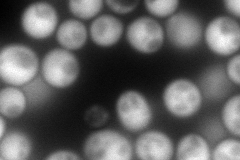
YOR251C
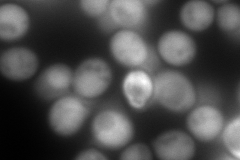
YOR251C
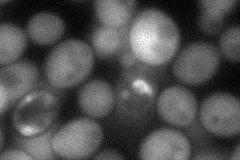
YOR251C

View description
Mitochondrial protein, required for formation of the 2-thio group of the 5-methoxycarbonylmethyl-2-thiouridine modified base in some tRNAs; has similarity to mammalian thiosulfate sulfurtransferase (rhodanese)
Localization:
Intensity:
Fold change:
Significance:
-
C’ GFP library in SD

cytosol25 -
N' NOP1pr-GFP in SD
cytosol282.378 -
N' TEF2pr-mCherry in SD
cytosol419.349 -
N' NATIVEpr-GFP in SD

cytosol41.803 -
N' TEF2pr-VC and Cyto-VN in SD
cytosol74.8891 -
C’ GFP library in SD+DTT

cytosol25.011No -
C’ GFP library in SD+H2O2

cytosol22.790.91No -
C’ GFP library in Starvation Media

cytosol25.821.03No -
C’ GFP library on the background of Pup2-DaMP

cytosol -
C’ GFP library on the background of CCT mutant

cytosol28.38671.13524No
